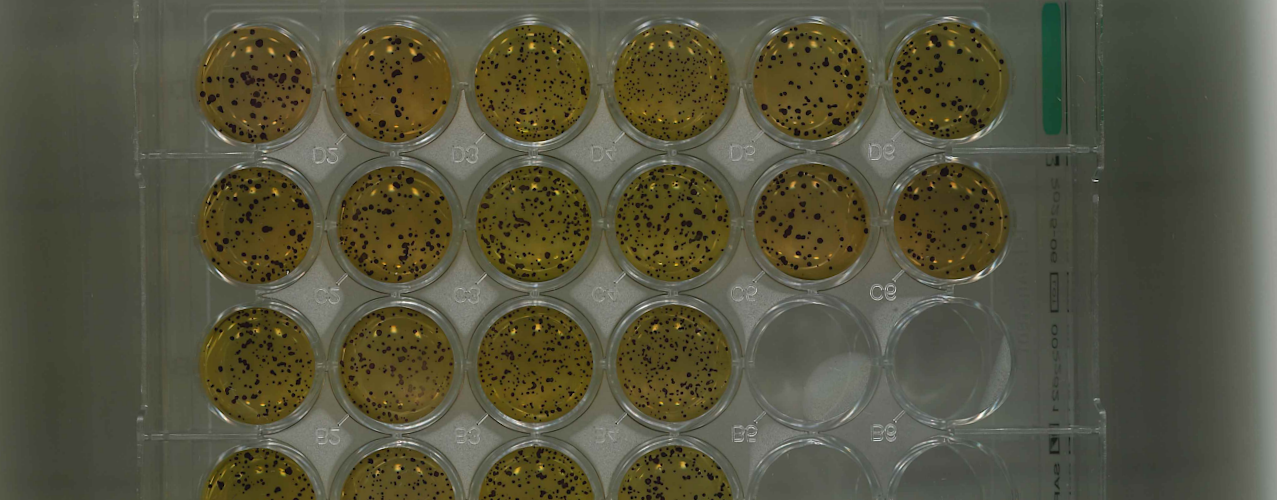

Frequenz und prognostische Bedeutung von ZNS Befall bei Non-Hodgkin-Lymphom- Rezidiven im Kindes- und Jugendalter
Das Non-Hodgkin Lymphom (NHL) stellt die vierthäufigste Tumorerkrankung im Kindes- und Jugendalter dar. Mittels aktueller Therapieprotokolle können in der Erstlinientherapie Überlebensraten von nahezu 90 % erreicht werden. Rezidive hingegen zeigen zumeist Überlebensraten von unter 30 %. Ein relevanter Faktor in Bezug auf Rezidiv- und Überlebensrate stellt der Befall des zentralen Nervensystems (ZNS) dar. Die aktuelle Datenlage der Rezidiverkrankungen und des Stellenwerts des ZNS-Befalls ist, gerade im Hinblick auf die Subentitäten der NHL, begrenzt. Mittels retrospektiver Analyse einer multizentrischen NHL-Rezidiv-Kohorte sollen Rückschlüsse auf Frequenz und prognostische Bedeutung des ZNS-Befalls gelingen.
Aufgrund der Größe der vorhandenen Datenbasis kann die Auswertung nach NHL-Subentitäten unterteilt erfolgen.

Die Rolle von TP53 in der Pathogenese des pädiatrischen Burkitt Lymphoms
In eigenen Vorarbeiten konnten wir rekurrente TP53 Mutationen bei Patient:innen, die am Burkitt Lymphom erkrankt sind, nachweisen. Interessanterweise waren TP53 Mutationen statistisch signifikant mit einem erhöhten Rückfallrisiko und somit mit einer schlechteren Prognose assoziiert. Ziel des Projektes ist die biologische Bedeutung von TP53 für Pathogenese des pädiatrischen Burkitt Lymphoms auf molekularer Ebene zu analysieren. Dazu wurde ein in-vitro Zellmodell in Burkitt Lymphom Zelllinien erarbeitet, um den Einfluss der verschiedenen TP53 Mutationen vor dem Hintergrund bekannter molekulargenetischer Signalwege zu charakterisieren.
Ansprechpartner: Anna Häntzschel, Dr. Marcel te Vrugt

Unterschiede in der Chemosensitivität von Zellen mit p53-Hotspot Mutationen
Protein 53 (p53) dient als einer der wichtigsten Regulatoren bei DNA-Schädigung, dessen Gen in vielen Krebserkrankungen mutiert ist. In diesem Projekt wird das Ansprechen von Burkitt Lymphom Zellen, die die wichtigsten p53-Mutationen (sog. Hotspot Mutationen) ausprägen, auf diverse Chemotherapeutika anhand von Viabilitätsassays untersucht. Als Ziel liegt hierbei die Optimierung der Therapie je nach p53-Mutationsstatus im Vordergrund.
Ansprechpartner*innen: Marc Hotfilder, Anna Häntzschel

Funktionelle Charakterisierung neuer NOTCH1-Fusionsgene bei T-Lymphoblastischen Lymphomen
Der Studiengruppe ist es kürzlich erstmals gelungen, eine bestimmte Genveränderung, die TRB::NOTCH1-Genfusion, bei T-LBL Fällen nachzuweisen. Gleichzeitig konnte gezeigt werde, dass diese Veränderung mit einem deutlich erhöhten Risiko für einen Rückfall der Erkrankung assoziiert ist. Diese Entdeckung ist ein zentraler Beitrag zur molekularen Charakterisierung von T-LBL.
Das von Marie Heider durchgeführte Projekt baut direkt auf dieser Vorarbeit auf. Ziel ist es, im Labor zu untersuchen, wie sich die neu entdeckte Genfusion auf Krebszellen auswirkt: konkret soll erforscht werden, wie das Fusionsgen das Zellwachstum, bestimmte Signalwege und die Reaktion auf Medikamente beeinflusst. Eine weitere Frage ist, ob und wenn ja, wie sich die biologische Wirkung von anderen bekannten NOTCH1-Mutationen unterscheidet.
Das Projekt wird gefördert durch die Deutsche Krebshilfe.
Ansprechpartnerin: Marie Heider

In-vitro-Analyse potentieller genetischer Marker aus pädiatrischen Patienten mit lymphoblastischem Lymphom.
Das lymphoblastische T-Zell-Lymphom, kurz T-LBL, und die akute lymphatischen T-Zell-Leukämie, kurz T-ALL, entsteht durch die maligne Transformation der Vorläuferzellen von T-Lymphozyten. Beide Krebserkrankungen werden in der WHO-Klassifikation der lymphatischen Neoplasien zusammengefasst (T-LBLL).
Eine Studie unserer Arbeitsgruppe evaluierte die genomweiten Mutationen in 127 pädiatrischen T-LBL Patienten. Ein neuer potentieller genetischer Marker konnte identifiziert werden: KMT2D-Mutationen wurden vermehrt bei Patienten mit Rückfällen gefunden und könnten somit ein Indikator für eine schlechtere Progression sein. Des Weiteren konnte gezeigt werden, dass NOTCH1 und FBXW7 insgesamt die am häufigsten mutierten Gene in der Patientenkohorte darstellen.
In diesem Masterprojekt werden KMT2D, NOTCH1 und FBXW7 zunächst mit Hilfe der CRISPR-Cas9 Methode in T-ALL und T-LBL Zelllinien individuell ausgeschaltet. Wie sich dieser genetische „Knockout“ auf die Zellproliferation auswirkt, soll anhand verschiedener Methoden untersucht werden. Außerdem werden funktionelle Analysen durchgeführt, um die Rolle der oben genannten Gene in der Entstehung und Entwickelung von T-Zell-Lymphomen und Leukämien besser verstehen zu können. Darüber hinaus, sollen die Interaktionen dieser Indikatoren untersucht und neue Interaktionspartner identifiziert werden.
Auf langfristige Sicht, kann die biologische Analyse der krebsspezifischen Mutationen in diesen Genen zu einem tiefgründigerem Verständnis der Erkrankung und optimierter Indikation führen.
Ansprechpartner: Dr. Marcel te Vrugt

Lymphoblastische B-Zell Lymphome (pB-LBL): Kann Weniger mehr bedeuten? Retrospektive Analyse unterschiedlicher Therapien für Patienten mit lokalisierten pB-LBL
Precursor B-Zell Lymphome (pB-LBL) machen ca. 20-25% der lymphoblastischen Lymphome im Kindesalter und Jugendalter aus. Sie können lokalisiert (Stadium I-II) oder mit fortgeschrittener Ausbreitung (Stadium III-IV) vorkommen. Die in den letzten Jahrzenten durchgeführte Therapie basiert im Allgemeinen - mit einigen Anpassungen - auf Therapieregimen für akute lymphoblastische Leukämien (ALL).
Weltweit gibt es unterschiedliche Protokolle für die Behandlung dieser seltenen Erkrankung. Einige Protokolle sehen für alle pB-LBL unabhängig vom Stadium der Erkrankung alle Therapieelemente vor. Die Protokolle der NHL-BFM Gruppe sehen hingegen seit mehreren Jahren für Patienten mit lokalisierten Stadien (I und II) die Therapie ohne das Element „Re-Induction“ vor.
Ziel des aktuellen Projektes ist die Analyse dieser Patienten mit limitierten pB-LBL und deren Outcome. In der retrospektiven Analyse der Patienten, die gemäß der Protokolle NHL-BFM 95, EURO-LB02, des LBL Registers und des NHL-BFM Registers 2012 behandelt wurden, werden unter anderem Patientencharakteristika, das Overall Survival (OS), das Event-Free Survival (EFS) und Therapienebenwirkungen analysiert und mit publizierten Daten von Patienten verglichen. Interessant ist hierbei insbesondere der Vergleich der NHL-BFM Daten mit publizierten Daten anderer Studiengruppen, in denen Patienten mit lokalisierter Erkrankung kein reduziertes Therapieprotokoll erhalten.
Letzten Endes wird analysiert, ob man mit weniger Chemotherapie - und damit weniger Toxizität - vergleichbare Therapieerfolge erreichen kann.
Ansprechpartnerin: Laura Arias Padilla

Rituximab-Clearance bei pädiatrischen Patienten mit frühem aggressivem B-Zell-Non-Hodgkin-Lymphom
In den letzten Jahrzehnten konnte die Behandlung pädiatrischer Patienten mit reifem aggressivem B-Zell-Non-Hodgkin-Lymphom (B-NHL) systematisch verbessert werden, so dass die Gesamtüberlebensrate 80-90 % beträgt. Patienten mit refraktären/rezidivierenden Erkrankungen haben jedoch eine schlechte Prognose. Die derzeitigen Chemotherapieschemata in Kombination mit B-Zell-gerichteten Wirkstoffen, wie dem Anti-CD20-Antikörper Rituximab, verbessern die Ergebnisse für Hochrisikopatienten. Es gibt nur wenige Daten zu den einzelnen Parametern, die das Ansprechen auf Rituximab beeinflussen könnten, und zu den Bedingungen, die eine Anpassung der empfohlenen Dosis von 375 mg/qm erfordern könnten. Frühere Daten zeigen eine Korrelation zwischen einer hohen Tumorlast und niedrigen Rituximab-Serumspiegeln sowie niedrigeren Rituximab-Spiegeln bei erwachsenen Männern als bei Frauen.
Um die Wirksamkeit von Rituximab bei Kindern mit B-NHL durch Dosisanpassung zu optimieren, analysieren wir mögliche Parameter, die die individuelle Clearance von Rituximab beeinflussen.
Ansprechpartnerin: Ida Tölle

Folgen Sie auch gerne unserem Instagram-Account um mehr über unseren Laboralltag und Neuigkeiten aus der Studienzentrale zu erfahren!